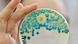
Klinische Mikrobiologie Immunologie Hygiene Petrischale Klinische Mikrobiologie Immunologie Hygiene Petrischale

Wann Sie wirklich Antibiotika nehmen müssen
18. November 2019
Was sind Antibiotika?
Antibiotika sind Arzneimittel, die Bakterien und andere Mikroorganismen abtöten (bakterizide Antibiotika) oder dafür sorgen, dass sie sich nicht weiter vermehren können (bakteriostatische Antibiotika). Antibiotika sind natürlich vorkommende Stoffwechselprodukte verschiedener Bakterien und Pilze, wie etwa das Penicillin. Einige Schimmelpilzarten stellen es her, um sich selbst gegen Bakterienbefall zu schützen.
Andere Antibiotika wurden im Labor entworfen oder chemisch verändert, um ihre Wirkungsweise zu verbessern. Unterschieden wird zwischen den Schmalspektrum-Antibiotika, die jeweils speziell gegen einen bestimmten Krankheitserreger wirken, und Breitband-Antibiotika, die gegen viele Bakterien wirken.
Wie wirken Antibiotika?
Indem Antibiotika Bakterien töten oder deren Wachstum hemmen, unterstützen sie das Abwehrsystem des Körpers. Sie greifen dabei unter anderem die Zellwand oder den Stoffwechsel dieser Mikroorganismen an. Penicilline stören zum Beispiel die Zellwandsynthese der Bakterien. Mit löchriger Zellwand sind die Erreger nicht lebensfähig und zerplatzen regelrecht.
Andere Medikamente verhindern, dass die Einzeller Eiweiße herstellen können, die sie dringend fürs Überleben brauchen. Oder die Substanzen blockieren Transportmechanismen in der Zellwand. So bricht das natürliche Gleichgewicht der Zellen zusammen. Wieder andere stören die Vermehrung der Erreger. Nach einer Weile sterben die noch verbliebenen Einzeller ab, neue können nicht entstehen.
Dies alles funktioniert allerdings nur bei Bakterien, gegen Viren sind Antibiotika nicht wirksam.
Wann sollten Antibiotika zum Einsatz kommen?
Schnupfen, Husten, Halsschmerzen und Fieber: Da sich die Symptome zu Beginn einer Erkrankung oftmals ähneln, ist es zunächst nicht klar, ob es sich um eine bakterielle oder um eine virale Infektion handelt.
Die meisten Erkältungskrankheiten und die Grippe (Influenza) werden durch Viren hervorgerufen, bei denen die Einnahme eines Antibiotikums nicht sinnvoll ist.
Mehr dazu: Was man über "Super-Keime" wissen sollte
Sinnvoll ist der Einsatz von Antibiotika dagegen, wenn Bakterien durch ein geschwächtes Immunsystem in den Körper eingedrungen sind und sich dort vermehren. Denn so können Entzündungen ausgelöst und Organe zum Teil dauerhaft geschädigt werden. Lungenentzündungen, Mandelentzündungen, Blasen- oder Hirnhautentzündungen werden meistens durch Bakterien ausgelöst. Hier ist der Einsatz von Antibiotika sinnvoll.
Um Resistenzen einzudämmen, sollten Antibiotika also nur eingesetzt werden, wenn es unbedingt nötig ist. Und eine Behandlung sollte niemals frühzeitig abgebrochen werden, weil die dann möglicherweise überlebenden Bakterien eine Gelegenheit bekommen könnten, gegen das Antibiotikum eine Resistenz auszubilden.
Warum wirken viele Antibiotika nicht mehr?
Wer eine bakterielle Infektion hat, der bekommt meist direkt ein Antibiotikum. Durch den massenhaften Einsatz wirken diese Medikamente aber oftmals nicht mehr, weil die Bakterien sich sehr schnell an die Antibiotika gewöhnen und eigene Abwehrmechanismen gegen Antibiotika entwickeln.
Zum Beispiel stellen die Bakterien neue Eiweiße her, die das Antibiotikum-Molekül zerschneiden und so unschädlich machen. Oder die Bakterien verändern ihre Zellwand so, dass das Antibiotikum nicht mehr ins Innere der Zellen gelangen kann.
Oft verändert der Erreger auch die Zielstruktur, an der das Antibiotikum andockt: Das Bakterium stellt dann beispielsweise ein anderes Eiweiß her, das zwar die gleiche Funktion in der Zelle übernimmt, aber unempfindlich gegen die antibakterielle Substanz ist.
Hat ein Bakterium einen solchen Ausweg gegen ein Antibiotikum gefunden, gibt es sein verändertes Erbgut an alle seine Nachkommen weiter. Bakterien können sogar durch bloßen Kontakt untereinander Erbgutstücke austauschen. So breitet sich die Resistenz immer weiter aus. Oft sind Erreger sogar gegen mehrere Antibiotika gleichzeitig gewappnet.
Weltweit sterben nach Angaben der Weltgesundheitsorganisation WHO etwa 700.000 Menschen jährlich an den Folgen von Antibiotika-Resistenz.
Was sind Reserve-Antibiotika?
Wenn Antibiotikaresistenzen auftreten oder eine besonders starke Infektion vorliegt, gibt es als Rückfallposition noch die sogenannten Reserveantibiotika, die Ärzte nur in kritischen Fällen einsetzen. Aufgrund des seltenen Gebrauchs hatten Bakterien noch keine Gelegenheit, Abwehrmechanismen gegen diese Substanzen zu entwickeln.
Die Reserveantibiotika sind aber keineswegs besser als Standardantibiotika. Häufig sind sie deutlich weniger wirksam, sind schlechter verträglich oder sind mit mehr Nebenwirkungen behaftet. Deshalb werden sie bei Menschen nur in Notfällen verschrieben.
Mehr dazu: Starke Zunahme resistenter Keime in Indien
Laut Weltgesundheits-Organisation (WHO) gilt etwa Colistin als eines der wichtigsten Reserveantibiotika. Colistin ist ein sehr altes Antibiotikum, das jahrzehntelang bei Menschen wegen starker Nebenwirkungen kaum noch eingesetzt wurde. Als Reserve-Antibiotikum sollte es laut WHO so wenig wie möglich eingesetzt werden, damit es seine Wirkung nicht verliert.
Tatsächlich aber werden Reserve-Antibiotika sehr häufig in der Massentierhaltung eingesetzt. Viele Ärzte sehen die Verwendung dieser Antibiotika für Tiere sehr kritisch.
Warum werden keine neuen Antibiotika entwickelt?
Stets neue Medikamente zu entwickeln, die das Bakterium noch nicht kennt, ist die einzige Möglichkeit, Resistenzen langfristig entgegenzuwirken und den Wettlauf gegen die Bakterien zu gewinnen. Trotzdem investieren Pharmaunternehmen inzwischen deutlich weniger in die Forschung an neuen Antibiotika.
Denn die Entwicklung eines neuen Antibiotikums kostet mehrere hundert Millionen Euro. Bei einer erfolgreichen Zulassung des Mittels kommen die Ausgaben für Herstellung, Vertrieb und Vermarktung hinzu.
Allerdings werden Antibiotika nur wenige Tage lang eingenommen und wenn die neuen Mittel sogar nur im Notfall eingesetzt werden sollen, verdienen die Konzerne kaum Geld. Da sind dann selbst für große Konzerne andere Forschungsfelder wie die Herstellung von Krebsmedikamenten oder von Mitteln gegen chronische Erkrankungen deutlich lukrativer.
Auch deshalb sollte die Politik aus Sicht vieler internationaler Experten die Entwicklung neuer Mittel stärker fördern – sei es in Pharmakonzernen oder in staatlich geförderten Forschungseinrichtungen.
Mehr dazu: 90 Jahre nach Penicillin: Artilysine könnten Antibiotika ablösen